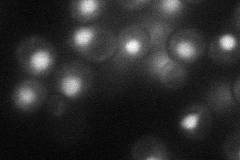
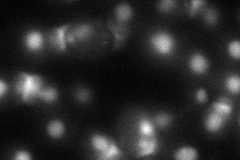
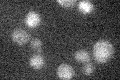

View description
Replication initiation protein that loads DNA pol epsilon onto pre-replication complexes at origins; checkpoint sensor recruited to stalled replication forks by the checkpoint clamp complex where it activates Mec1p; ortholog of human TopBP1
Localization:
Intensity:
Fold change:
Significance:
-
C’ GFP library in SD

nucleus18.78 -
N' NOP1pr-GFP in SD
nucleus32.2295 -
N' TEF2pr-mCherry in SD
nucleus49.056 -
N' NATIVEpr-GFP in SD

punctate18.8178 -
N' TEF2pr-VC and Cyto-VN in SD

nucleus27.2586 -
C’ GFP library in SD+DTT

nucleus19.11.01No -
C’ GFP library in SD+H2O2

nucleus19.221.02No -
C’ GFP library in Starvation Media
nucleus170.9No -
C’ GFP library on the background of Pup2-DaMP

nucleus -
C’ GFP library on the background of CCT mutant

nucleus20.01811.06564No
